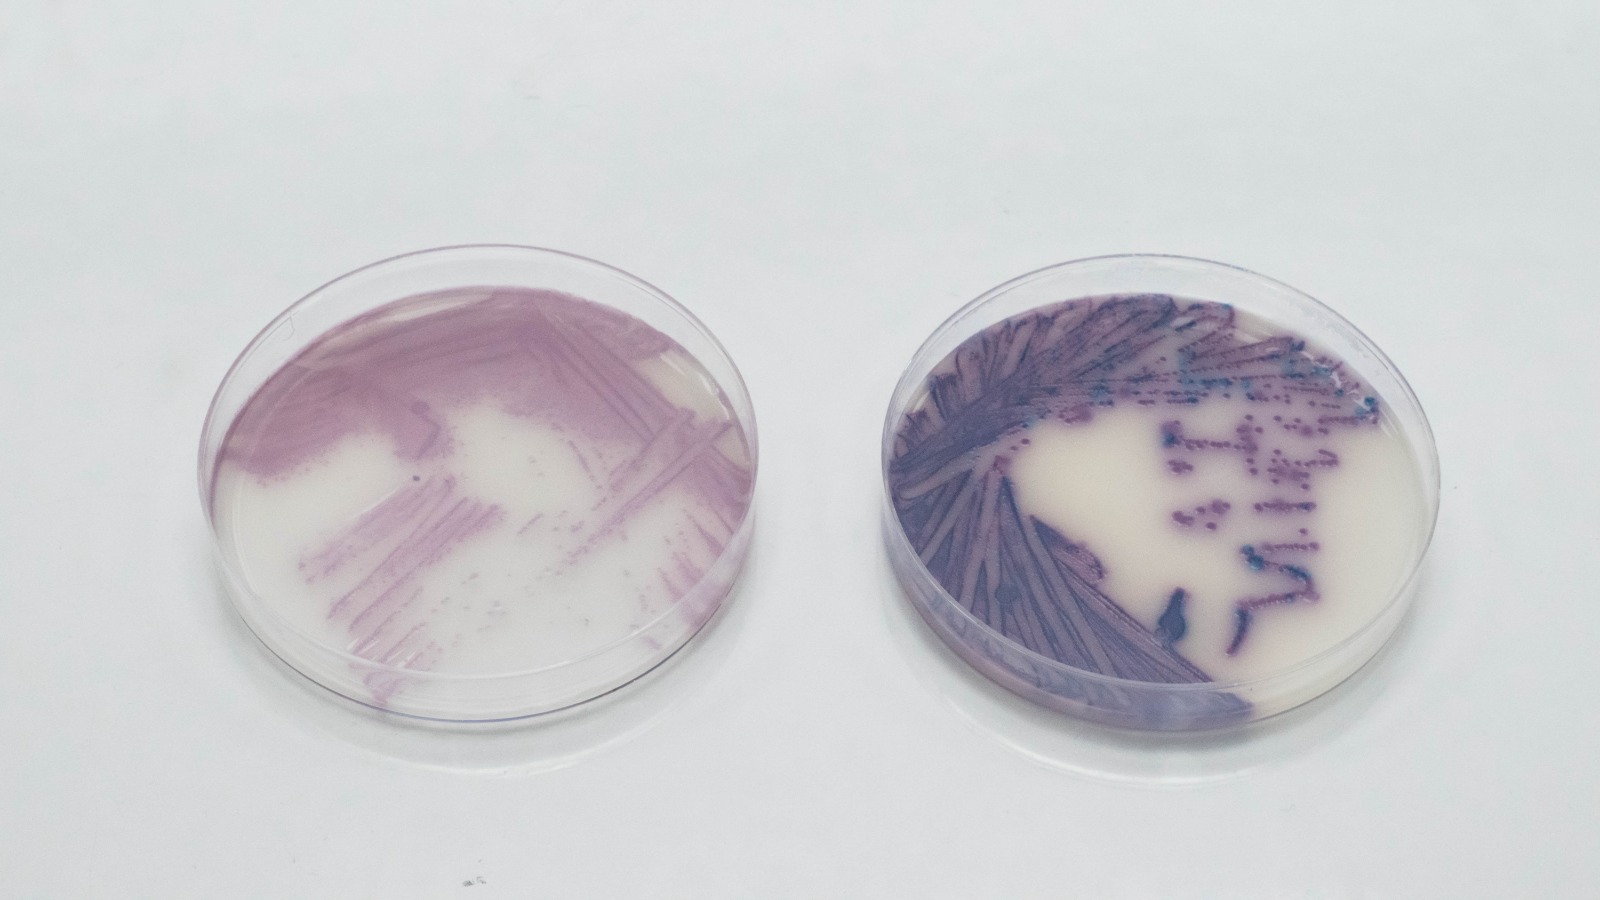

Tested. Trusted. Accurate.
Fast, accredited diagnostic testing nationwide.
Fast Turnaround
Accredited Testing
Actionable Insights

About SMT VET
Accredited. Experienced. Nationwide.
SMT VET is South Africa’s trusted partner in diagnostic testing, operating a SANAS - accredited and Department of Agriculture (DOA) - approved laboratory in Centurion and proudly registered with the South African Veterinary Council (SAVC). Since 2021, we have delivered microbiological, serological, molecular, and hygiene testing services with exceptional speed, accuracy, and reliability.
Our Services
Comprehensive Diagnostic, Microbiological, Serological, Molecular and Hygiene Testing that can service the Veterinary Industry Nationwide

Hygiene and Product Monitoring
Our hygiene and product monitoring services identify microbial contamination in air, water, surfaces, and farm environments, helping protect flock health, reduce pathogen spread, and maintain biosecurity compliance.
Read more...
Bacteriology
Our bacteriology services provide precise isolation and identification of aerobic, anaerobic, and micro‑aerophilic bacteria. While widely used in poultry diagnostics, these methods are equally applicable to general veterinary and environmental samples.
Read more...

Molecular Testing
Molecular testing services deliver rapid and accurate detection of avian and bacterial pathogens using PCR technology. These tests support poultry health management but can also be applied to broader veterinary and research needs.
Read more...

Serology
Our serology services provide comprehensive ELISA and HI testing for avian pathogens, supporting flock health monitoring, vaccination programs, and general antibody detection across species.
Read more...

Parasitology
Our additional testing services provide targeted analysis for egg, feed, and product quality. While primarily used in poultry, these tests can also support broader veterinary and agricultural needs.
Read more...
Why Choose SMT VET
Industry-Leading Speed
Results in as little as 3 days for positive release, consistently beating average turn-around times.
Trusted Accreditation
SANAS accredited and DAH approved, ensuring full compliance.
True Partnership
Nation-wide footprint with personal, expert support whenever you need it.
We believe diagnostic testing should be fast, accurate, and accessible.
So you can focus on protecting your brand, products, and the environment.

Our Process
From Sample to Results in 3 Easy Steps
Step 1: Tell Us What You Need
Share your testing requirements.
Step 2: Send Samples Securely
Submit through our client portal.
Step 3: Get Certified Results
Fast, accredited, actionable guidance.
Latest from SMT LABS
Our SANAS-accredited laboratories and Department of Agriculture approval ensure your results are fully compliant, legally defensible, and recognised nationwide.
Unseen Guardians and Hidden Threats: A Dive into Water Quality Testing
Water quality testing protects both people and the planet. By analysing chemical elements and microorganisms, SMT Labs ensures that drinking, industrial, and environmental water meet strict safety standards. Each test safeguards health and prevents contamination before it starts.
The Secret Social Lives of Microorganisms
Microorganisms form friendships, communicate, and even cooperate to survive — much like humans. From lichens and biofilms to slime molds and gene sharing, these invisible connections reveal the complex social world of microbes and how collaboration drives life itself.
Microorganisms vs AI: Shaping the Future of Life and Technology
Microorganisms are shaping the future of our planet just as much as artificial intelligence. From influencing climate change and ecosystem balance to advancing biotechnology and health, their interplay with AI offers powerful new ways to address global challenges and create a sustainable future.
Accreditations & Partners
Trusted by Regulators and Industry Leaders
Our SANAS-accredited laboratories and DAH approval ensure your results are fully compliant, legally defensible, and recognised nationwide.



Ready for reliable results?
Partner with SMT VET for fast, accredited testing you can trust.






